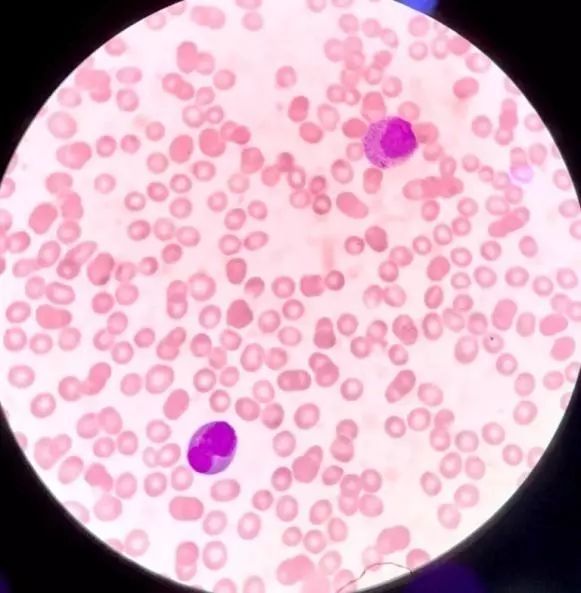
外周血细胞形态分析能查出什么病,外周血细胞形态能看出白血病吗
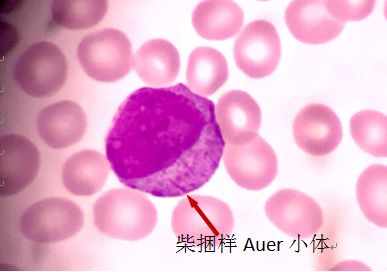
外周血细胞形态分析能查出什么病,外周血细胞形态能看出白血病吗
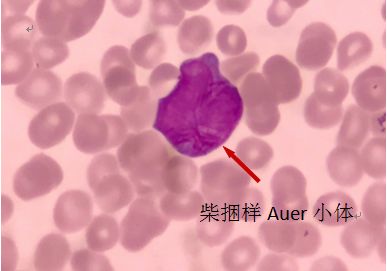
外周血细胞形态分析能查出什么病,外周血细胞形态能看出白血病吗

本文转载自微信 公众号“检验医学”(labweb)
作者:刘小晴
单位:中山大学附属第八医院(深圳福田)
01
案例经过
2018年12月24日中午11点多,急诊送来一个血常规,诊断急性上呼吸道感染?上仪器检测白细胞(WBC)1.7×109/L,血小板(PLT)16×109/L,仪器报警原始细胞,直方图散点图显示异常见图1。

图1 贝克曼DXH800仪器结果显示图
02
案例分析
这些数据满足我科室血常规复检规定,于是立马制做血涂片,等待干片时候凭着自己多年临检经验感觉不妙,想起了曾经在形态会议上学习到的对白细胞总数较低标本离心后吸取白细胞层涂片方法可以提高细胞检出率(文末有详细介绍),于是着手了一番后,耐心的寻找着有核细胞,于是就找到了下面这些细胞(图2、图3):
图2 外周血涂片瑞氏染色 10×100

图3 离心白细胞层涂片瑞氏染色 10×100
由于外周血白细胞数低下,在镜下寻找有核细胞非常不容易,经过离心白细胞层制片后提高了细胞的检出率。继续寻找,外周血涂片,找到了如下异常的细胞:

图4 瑞氏染色10×100手机放大拍摄图片
看到这些异常的细胞,我眉头紧锁,心中不免惆怅,这可不是普通的感冒呀!这可是来势汹汹的白血病细胞啊!
于是立马查询此患者情况及其他相关检测:此患者29岁,在后厨工作,发烧不退3天,全身乏力于急诊科就诊,初诊急性上呼吸道感染?目前只做了抽血常规,凝血检测,于是我立马追踪凝血报告,如下:

图5 凝血报告
凝血报告D-二聚体97988 ug/L,明显升高;而纤维蛋白原0.8 g/L,明显减少,3P阳性提示有DIC出血的倾向,这些凝血报告已经出现了急性早幼粒细胞白血病特征性的改变了。
结合外周血异常白血病细胞和典型的凝血报告数据,在12点15分我慎重发出了报告:结果已镜检复查,请临床进一步骨髓和基因相关检测排查M3。并及时向急诊科上报了危急值!
经过追踪,患者当天下午就被紧急骨髓穿刺并抢救治疗,后骨FISH:PML-RARA融合基因95%阳性,染色体核型分析结果46,XY,t(15;17)(q22;q21)。后经过血液科的精心治疗和患者的顽强拼搏,患者病情慢慢好转了,2019年2月22始日的血常规血象已几乎达正常。我们为患者的不幸患病而揪心,也为患者的此次幸运捏把汗!
我们了解一下什么是M3,M3是急性早幼粒细胞白血病(APL)的通俗叫法。是一种特殊类型的急性髓系白血病(AML),绝大数患者具有特异性染色体易位t(15;17)(q22;q12),形成PML-RARa融合基因。
APL易见于中青年人,平均发病年龄为44岁,其主要分子机制是蛋白产物导致细胞分化阻滞和凋亡不足。APL通常起病急骤,仅数天到数周,进展迅速,来势凶险。起病及诱导治疗过程中很容易发生出血和栓塞,早期死亡率非常高,曾被认为是最凶险的白血病。故APL的早期诊断和及时干预非常重要。
近三十年来,由于全反式维甲酸(ATRA)及砷剂的规范化临床应用,APL已成为基本不用进行造血干细胞移植即可治愈的白血病[1]。
由于APL的早期出血风险远远高于其他血液系统白血病,作为临床一线的血常规岗位的我们,早期镜检发现异常早幼粒细胞对于疾病的早期发现,为病人赢取抢救时间起着非常重要的角色。
既往由于各种原因导致漏诊而错失治疗时机的惨痛病例也时有耳闻。一张小小的血涂片,往往可以准确获取患者疾病重要信息,我们检验一线的每一员,都要重视镜检,参与镜检,做好镜检,为临床的准确诊断及早治疗奉献我们的力量!
03
总结与心得
检验一线的亲们如果单独看这些特异的细胞,大多还是可以快速认出来的。但是因为APL初发多以外周血三系减低为特点,加上临床标本量大,工作任务重,难免做不到细致,此病的漏检事件还是常有发生的。
在这里分享一个在平时学习会议上学习到的对于低白的标本处理的一个小技巧。(陈雪艳老师学习会议上的低白处理方法及Buffycoat涂片法示意图)
Buffycoat涂片法(离心全血分离白细胞和血浆的方法):
1、静脉采集的EDTA抗凝全血必须在采集后2小时内处理;
2、抗凝血在离心机(2200rpm或1000g)的速度离心10分钟,弃去血浆,吸取白细胞层(Buffycoat)涂片,干燥后瑞氏染色镜检。

此次还有一个小惊喜,得知此患者来自我的美丽家乡。在这来自五湖四海的大深圳,能有缘为老乡做一点事情感到非常的自豪与感恩啊!
参考文献:
[1]中国急性早幼粒细胞白血病诊疗指南[J],2018年版,中华血液学杂志,2018,39(3):179-183.
